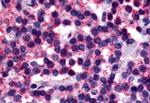
Calcitonin Receptor Antibody in Immunohistochemistry (Paraffin) (IHC (P))

Search
Invitrogen
Calcitonin Receptor Polyclonal Antibody
{{$productOrderCtrl.translations['antibody.pdp.commerceCard.promotion.promotions']}}
{{$productOrderCtrl.translations['antibody.pdp.commerceCard.promotion.viewpromo']}}
{{$productOrderCtrl.translations['antibody.pdp.commerceCard.promotion.promocode']}}: {{promo.promoCode}} {{promo.promoTitle}} {{promo.promoDescription}}. {{$productOrderCtrl.translations['antibody.pdp.commerceCard.promotion.learnmore']}}
图: 1 / 2
Calcitonin Receptor Antibody (PA5-33379) in IHC (P)

Please note: We are reviewing Western blot images included in the antibody testing data in our catalog, including those provided by third parties. Unless expressly labeled or annotated as “raw-unedited”, Western blot images included in the antibody testing data in our catalog may have been edited, optimized or otherwise adjusted for presentation.
产品信息
PA5-33379
种属反应
宿主/亚型
分类
类型
抗原
偶联物
形式
浓度
规格
纯化类型
保存液
内含物
保存条件
运输条件
RRID
产品详细信息
Percent identity with other species by BLAST analysis: Human (100%) Gorilla, Marmoset (95%) Gibbon, Monkey (90%) Rabbit (85%) Panda, Dog, Horse (80%).
靶标信息
The Calcitonin Receptor inhibits bone resorption. This receptor is expressed during development and is involved in morphogenesis. Three alternatively spliced Calcitonin Receptor isoforms have been identified. In addition to binding calcitonin, the Calcitonin Receptor can complex with RAMP3 (receptor activity modifying protein) to bind amylin, which regulates pancreatic islet function and is involved in Type II diabetes. The Calcitonin Receptor has been reported in artery, blood, bone, brain, kidney, lung, placenta, prostate, skeletal muscle, and thyroid. ESTs have been isolated from bone, embryo, kidney, and melanocyte/uterus/fetal heart libraries.
仅用于科研。不用于诊断过程。未经明确授权不得转售。




